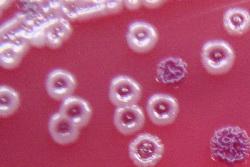

La mélioïdose, une maladie infectieuse qui peut tuer presque autant que la rougeole et beaucoup plus que la dengue, serait beaucoup plus répandue qu'on ne le pensait jusqu'ici, avertit une étude publiée lundi.

La maladie est endémique en Asie du sud-est et au nord de l'Australie. Un nombre croissant d'infections a été rapporté ces dernières années en Europe.
La forme aiguë de la maladie, qui se transmet de l'animal à l'homme, se manifeste par des infections respiratoires (pneumopathies nécrosantes) et une septicémie (avec fièvre élevée, céphalées, diarrhées, vomissements, lésions cutanées et abcès).
Selon les auteurs de l'étude, publiée lundi dans la revue Nature Microbiologie, la maladie qui se propage surtout par l'intermédiaire d'animaux, est difficile à diagnostiquer. La bactérie est de surcroît résistante à de nombreux antibiotiques.
La maladie "tue beaucoup de gens de façon silencieuse", a expliqué à l'AFP Direk Limmathurotsakul, de l'unité de recherche en médecine tropicale de l'université Mahidol à Bangkok, co-auteur de l'étude.
"C'est une maladie sous estimée et sous analysée" ajoute-t-il.
En étudiant les données publiées depuis 1910, les chercheurs ont découvert que la maladie était largement sous estimée dans les 45 pays où elle est présente et dans 34 autres où elle n'a jamais été répertoriée.
Selon leurs estimations, sur les 165.000 nouveaux cas de mélioïdose en 2015 dans le monde, 89.000 ont abouti à des décès.
Le taux de mortalité – environ 70% - est étonnamment élevé, et même supérieur à la grippe aviaire.
Les formes chroniques se caractérisent par des abcès et des lésions suppuratives au poumon (simulant une tuberculose), au foie, à l'intestin, à la rate, mais sur la peau et dans le cerveau.
La mélioïdose est avec le VIH et la tuberculose, l'une des trois premières causes de mortalité résultant d'une maladie infectieuse dans certaines régions d'Asie du sud-est.
Le bacille burkholderia pseudomallei à l’origine de la maladie, est présent dans le sol et peut pénétrer dans le corps par écorchures, plaies ou brûlures souillées mais aussi par ingestion ou inhalation.
Compte tenu des déplacements de populations et des agents pathogènes, la mélioïdose pourrait bien se développer à l'avenir dans des zones non encore touchées, ajoutent-ils avant d'inviter les autorités sanitaires à accorder une plus grande priorité à cette maladie.
En Thaïlande, elle est souvent contractée par des riziculteurs qui travaillent plusieurs heures par jour dans les rizières.
Selon Direk Limmathurotsakul, le dépistage de l’infection nécessite un travail de laboratoire avancé, ce pour quoi la Thaïlande est mieux équipée que beaucoup de ses voisins moins développés comme le Vietnam, la Birmanie et le Cambodge.
Mais même avec ses hôpitaux et laboratoires de pointe, les chiffres du gouvernement font état de seulement sept décès de mélioïdose en 2015, un bilan qui semble largement sous-estimé, dit-il.
"Le bacille est difficile à diagnostiquer, difficile à traiter et résistant à nombre d’antibiotiques. Il nous faut davantage de sensibilisation et d’outils de diagnostics", estime Direk.
AFP (http://www.lepetitjournal.com/bangkok) lundi 11 janvier 2016
{loadposition 728-2_bangkok-article}







